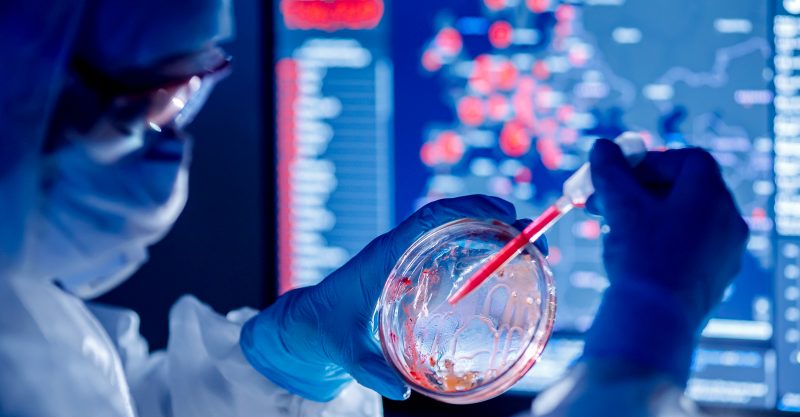

Republicanos y demócratas aseveran que se necesitan respuestas para evitar que la tragedia se repita. Solo falta la firma de Biden en el proyecto de ley mientras China exige su anulación
Los documentos clasificados del Departamento de Energía —que salieron a la luz en febrero pasado y plantearon que la pandemia por coronavirus «probablemente surgió de una fuga de laboratorio»— desataron un efecto dominó que no sólo pone en jaque al Gobierno de Joe Biden, sino al mismísimo régimen chino y a la Organización Mundial de la Salud (OMS).
En este sentido, la Cámara de Representantes de Estados Unidos aprobó con 419 votos a favor y cero en contra, un proyecto de ley que obligaría a Avril Haines, directora de Inteligencia Nacional, a desclasificar toda la información recopilada sobre los orígenes de la pandemia por coronavirus y su relación con el Instituto de Virología de Wuhan.
Se sabe que el primer caso fue detectado en la ciudad de Wuhan, China. Pero no hay certezas del cómo, es decir, si tuvo un origen natural u ocurrió por una fuga de laboratorio. La primera teoría la defendieron hasta el cansancio figuras como Anthony Fauci, el principal epidemiólogo de EE. UU., pero más tarde esa hipótesis se desinfló. Ahora es la fuga de laboratorio la protagonista de esta historia y de intensas acusaciones.
Republicanos y demócratas en el Congreso acordaron que se necesitan respuestas para evitar que la tragedia se repita. Solo falta la firma de Biden en el proyecto de ley.
Deficientes investigaciones
«Fauci supo ya en marzo de 2020 que el coronavirus se filtró de un laboratorio en Wuhan, China. Pasó los siguientes tres años esquivando, engañando, caracterizando erróneamente la posibilidad e incluso usando dólares de los contribuyentes estadounidenses para pagar estudios para desacreditar eso mismo», mencionó el congresista republicano August Pfluger.
La votación de la Cámara Baja fue unánime entre demócratas y republicanos, igual que lo fue en la Cámara Alta hace nueve días. El proyecto de ley en cuestión fue presentado por el senador republicano Josh Hawley, luego de que el Departamento de Energía decidiera inclinarse por la fuga de laboratorio. Aunque le asignó el calificativo de «baja confianza», el hecho de que la agencia apoyara esta hipótesis hizo que la política estadounidense se revolucionara de nuevo, exigiendo rendiciones de cuentas serias.
Biden dio en mayo de 2021 un plazo de 90 días a la inteligencia de EE. UU. para investigar el origen del mortal virus. Aunque de allí no salieron resultados contundentes, al menos eso demostró la Casa Blanca. Tampoco sirvió de mucho la comisión de expertos que la OMS envió a China porque dichos científicos solo pudieron acceder a datos incompletos, y desde la organización de salud no hubo un reclamo firme al comunismo de Xi Jinping.
China observa a EEUU
Mientras que el Congreso ya cocinó el proyecto y el país está atento a la firma de Biden, desde Pekín observan lo que está pasando. Tanto así que según Washinton Examiner, Li Xiang, consejero de la embajada china en EE. UU, envió carta a la oficina del senador Hawley para exigirle que retire el proyecto de ley.
Además del Departamento de Energía, la Oficina Federal de Investigación (FBI) también afirma que la pandemia del coronavirus se originó por una fuga de laboratorio y su director Christopher Wray aseveró hace pocos días lo siguiente:
“Solo haré la observación de que el gobierno chino, me parece, ha estado haciendo todo lo posible para tratar de frustrar y ofuscar el trabajo aquí, el trabajo que estamos haciendo, el trabajo que nuestro gobierno de EE. UU. y socios extranjeros cercanos estás haciendo. Y eso es desafortunado para todos”.